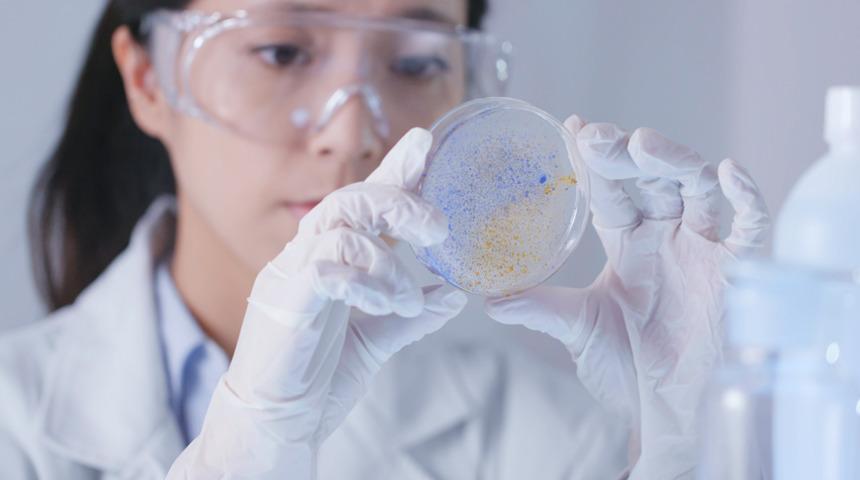
Kısırlık tedavisinde yeni umut: Elektrik aktivasyonu

Son 10 yıldır, erkek kısırlığının tedavisinde çığır açan teknolojik gelişmelere bir yenisi daha eklendi: Elektrik aktivasyonu. Uzmanlar, bu yöntemle özellikle menide hiç canlı sperm hücresi bulunmayan veya olgun olmayan sperm hücresi bulunan erkeklerin dahi çocuk sahibi olabileceğine dikkat çekiyor.
Genel kısırlık nedenlerine bakıldığında %30-35 kadarının erkek kaynaklı olduğu görülüyor. Sperm sayısındaki azlık, hareket sorunları veya spermdeki yapısal sorunlar, erkek kısırlığının ana sebeplerini oluşturuyor. Bu gruptakilerin yaklaşık üçte birinde, menide canlı sperme rastlanmıyor. Bu duruma Azoospermi adı veriliyor. Türkiye’deki üreme tıbbının öncülerinden biri olan Centrum Clinic Kadın Sağlığı ve Tüp Bebek Merkezi Kadın Hastalıkları ve Doğum Uzmanı Prof. Dr. Recai Pabuçcu, erkek kısırlığı ve tüp bebekte elektrik aktivasyonu dönemi hakkında önemli değerlendirmelerde bulundu.
TOPLUMUN YÜZDE 1'İNİ İLGİLENDİRİYOR
Kısırlık sorunu ile doktora başvuran 100 erkekten 15’inde rastlanılan azoospermi toplum genelinde 100 erkekten 1’inde görülüyor. Bu erkeklerin mutlaka iki kez sperm vermesi ve tanının testler sonucu netleştirilmesi gerektiğini belirten Prof. Dr. Recai Pabuçcu, tek bir örneğin yeterli olmadığını ve eğer tanı netleştirildi ise nedene yönelik tetkiklerin yapılması gerektiğini söyledi.
Pabuçcu, “Azoospermi olgularının %30-40 kadarında sperm üretimi oluyor ancak kanallarda tıkanıklık var, yani sperm dışarı atılamıyor. Bu durumda, çeşitli teknikler ile sperm elde etmek kolay ancak kalan %60-70 kadar olguda spermlerin üretiminde bozukluk olabilir ki bu durumda mutlaka genetik ve hormonal inceleme yapılarak uygun olgulara hormanal tedavi verilmelidir.

Üretim sorunu var ise, bu olgularda hormonal tedaviyi takiben, TESE olarak adlandırdığımız, testislerden cerrahi yöntem ile sperm elde edilmesi işlemi uygulanıyor. Bu işlemden sperm elde etme olasılığımız yaklaşık %30-40. Kalan büyük bir kesimde maalesef sperm elde edilemiyor. Bu da çiftlerde ciddi bir hayal kırıklığı yaratıyor. Bazen de olgun sperm değil de öncül sperm hücreleri elde ediliyor. Bu hücrelere genel olarak yuvarlak sperm hücreleri adı veriliyor. Bu öncül-yuvarlak sperm hücreleri ile yapılan tüp bebek tedavisinde başarı neredeyse sıfır.” dedi.
ELEKTRİK AKTİVASYONU YÖNTEMİ İLE 90 SAĞLIKLI BEBEK
Öncül sperm hücreleri, TESE işlemi uygulanmış azoospermik olguların birçoğundan elde ediliyor ancak bu hücrelerin yumurtaları dölleme kapasiteleri oldukça zayıf. Geçtiğimiz yıllarda Japonya’da, yeni bir teknoloji ile bu öncül spermlerin yumurtayı dölleme kapasiteleri artırıldı. Elektrik aktivasyonu tam da burada devreye giriyor. Elde edilen yuvarlak-öncül sperm hücreleri, yumurta içine verilmeden önce özel birtakım süreçlerden geçiriliyor ve sonrasında yumurta ile birlikte elektrik akımına maruz bırakılıyor. Bu yönteme de kısaca elektrik akımı ile aktivasyon adı veriliyor.
Bu yöntem ile bugüne dek 90 (doksan) canlı bebek elde edildi. Çok yeni yapılan bir çalışmada da bu bebeklerin 2 yaşlarına kadar herhangi bir olumsuz durum ile karşılaşmadıkları gözlemlendi. Yani azoospermik bir erkekte, olgun sperm hücresi yok ama yuvarlak öncül hücre var ise, elektrik akımı ile sağlıklı bebek şansı da var. Bu teknoloji, ilerleyen dönemde azoospermik erkeklere umut ışığı olacak gibi görünüyor.